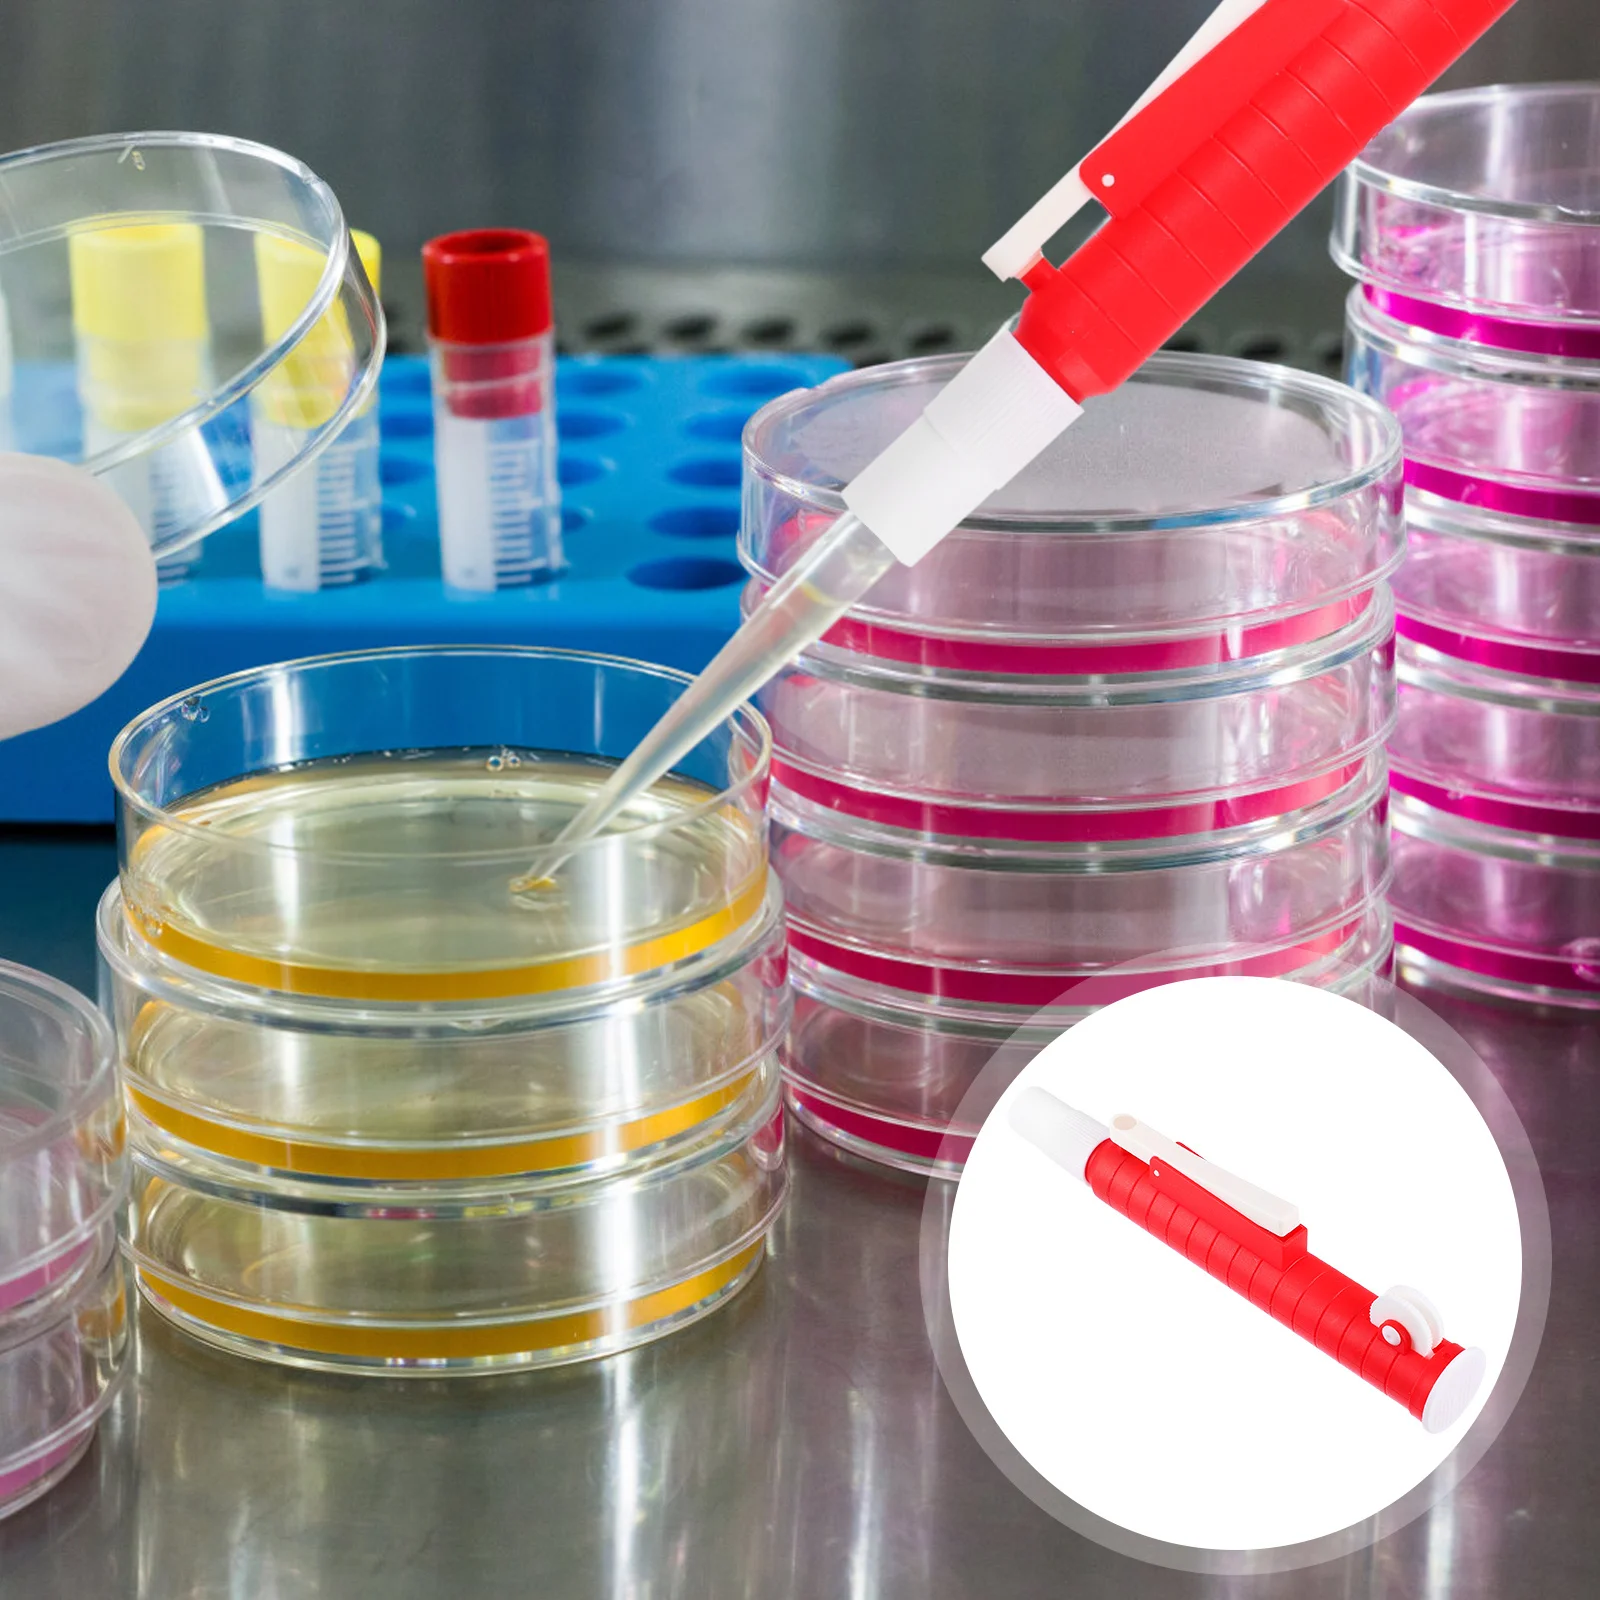

2021 Новый светодиодный фонарь, милый ночник, настольная лампа для детской комнаты, спальни, подарок, вечеринки, украшения для дома, Питание от...













артикул: 1005003711797943
ЗГІДНО З НАШИМИ ДАНИМИ, ЦЕЙ ПРОДУКТ ЗАРАЗ НЕ ДОСТУПНИЙ
$25.83
Доставка з: Китай
Характеристики
commissionRate: | 5.38% |
discount: | 50% |
Графік зміни ціни & курс обміну валют
Користувачі також переглядали

$18.25
Motorcycle Forged Aluminum Rear Brake Pedal Lever For KTM SX SXF EXC EXCF XC XCF XCW XCFW TPI SIX DAYS 125-500 2017-2023 2024
aliexpress.ru
$25.75
For Dewalt FLEXVOLT 20V/60V MAX Battery 12Ah DCB609 Lithium-ion DCB606 DCB612 DCB609 DCB205 DCB200 DCB182 Battery for Dewalt 20V
aliexpress.ru
$923.20
Задний спойлер из углеродного волокна VRS Style GT86 для Toyota GT86 brz, заднее хвостовое крыло, автомобильные аксессуары
aliexpress.ru
$32.35
Ремкомплект Тормозного Суппорта С Поршнем Переднего (Поршень О 46 Mm, Суппорт Brеmbо). DEQ
goods.ru
$16.13
fashion 18k gold plated diamond rhinestone pearl stud earrings for lady women party wedding lovers gift engagement jewelry for bri9768572, Golden;silver
dhgate.com
$16.73
cloocl genshin impact mens t-shirts short sleeve men clothing hip-hop style t shirts 3d print shirt, White;black
dhgate.com
$25.90
Многофункциональная отвертка JERXUN, комбинированный набор, маленькая отвертка Phillips Plum, инструменты для технического обслуживания iPhone и комп...
aliexpress.ru
$60.56
JNKET New Dermis Мужская сумка деловая Повседневная вместительная сумка-Конверт Сумка-клатч
aliexpress.ru
$71.99
Темно-синий летний мужской костюм на заказ двубортный смокинг для жениха костюмы жениха Блейзер 2 шт. (пиджак + брюки + галстук)
aliexpress.ru
$79.90
Новое поступление, мужские смокинги для жениха с одной кнопкой, мужские костюмы для свадьбы/выпускного вечера, блейзер (пиджак + брюки + жиле...
aliexpress.ru
$416.93
Китайский лук китайского традиционного фольклорного шнура Профессиональный Музыкальный Чехол аксессуары китайский музыкальный инструме...
aliexpress.ru
$587.21
ITOP гриль для барбекю, уличный угольный жаровня с электрическим мотором 110 В, кронштейн 220 В ~ 240 В, вилка для мяса, жаровня, барбекю, гриль-машин...
aliexpress.ru
$48.00
1 шт. застежки аксессуары для изготовления ювелирных изделий своими руками медные кубические циркониевые застежки для женщин ручной работы...
aliexpress.ru
$28.50
Винтажная гирлянда G4 с 20 соединяемыми лампочками, гирлянда с шариками, 100 светодиодов, рождественские сказочные огни для улицы, внутреннего ...
aliexpress.ru
$26.98
Товары для домашних животных зимняя сохраняющая тепло розовая собачья гнездо мягкая хлопковая набивка съемная и моющаяся кровать для коше...
aliexpress.ru
$47.18
USB C концентратор 12 в 1 VGA RJ45 Gigabit Ethernet адаптер питания Dock PD зарядное устройство 831D
aliexpress.ru
$49.00
Super Tenere ABS RAID EDITION XTZ1200 Motorcycle FOR YAMAHA XT1200Z XT1200ZE SUPER 2010-2021 TENERE Front Fork Guards Protection
aliexpress.ru
$11.49
Худи в стиле Харадзюку с капюшоном Hunter X Hunter Gon, Забавный пуловер с рисунком аниме, повседневные Модные топы, винтажная одежда
aliexpress.ru
$1,094.63
Современная искусственная лампа с полкой, индивидуальная креативная прикроватная лампа для спальни, Настольная Напольная Лампа для Кабине...
aliexpress.ru
$45.00
Сценические куклы 1:64, танцующие носильницы Ганы, сделай сам, стереоскопические украшения для кукольного домика, модель диорамы, миниатюрны...
aliexpress.ru
$11.39
Yuxin Little Magic SQ-1 Магнитный с черной стороной SQ1 Cubo Magico головоломка Square-1 магический куб обучающие игрушки для детей Square 1
aliexpress.ru
$1.37
Универсальный ключ Треугольники переключатель ключ, дюймовый стандарт гаечные ключи Лифт клапан электрический ключ для шкафа для электрич...
aliexpress.ru
$1.76
New Ceramic Coating Car Wax Polish Spray Waterless Hydrophobic Car Polishing Spray Nano Wash Coating Protection Hydrophobic D6V0
aliexpress.ru
$25.26
Погружной ручной блендер 4 в 1 с мощным контролем скорости, блендер, взбиватель молока, взбиватель яиц, венчик для детского питания, вилка ста...
aliexpress.ru
$27.72
Новинка 2021, модная мужская Толстовка Infiniti с логотипом автомобиля, повседневная Высококачественная Хлопковая мужская куртка с капюшоном, фл...
aliexpress.ru
$26.21
Джинсы мужские зауженные рваные, брюки из денима стрейч, с вышивкой, с дырками, брюки в байкерском стиле, белые, синие, черные
aliexpress.ru
$15.00
Новинка 2021, корейское платье-кофта Dongdaemun, Женская длинная юбка из двух предметов с разрезом
aliexpress.ru
$7.09
USB 3,0 Hub адаптер 5 Гбит/с, высокая Скорость концентратор 7 в 1 разветвитель адаптер для ноутбука Компьютерные аксессуары
aliexpress.ru
$41.30
Военный немецкий танк Technik, строительные блоки, совместимые с 2 мировыми войнами, армейские наборы, городской солдат, полицейское оружие, кир...
aliexpress.ru
$2,414.20
JP S0524 11" Tibet Buddhism Red Coral turquoise Bronze Gild Green Tara Goddess Statue B0403
aliexpress.com
$11.65
2 Piece Set Women Outfit 2025 Spring Autumn Fashion Geometric Print Stand Collar Long Sleeve Zip Up Top Casual Sporty Pants Set
aliexpress.com
$4.28
Instrument Pipeline Liquid Extractor Pipette Ear Dropper Pipettes Silicon Lab Filler Pump
aliexpress.com
$16.41
NEEWER Basics Pocket 3 Extension Adapter Mount Kit Compatible with DJI Osmo Pocket 3 for DSRL Digital Camera Vlogging GP-68
aliexpress.com
$1.09
Silicone Cap Replacement Protective Cover For Hair Dye Soft Antistaining Cover Head Covering Costume
aliexpress.com
$11.74
The Boogeyman Tshirt - The Boogeyman Hoodies - The Boogeyman Sticker T-Shirt printed t shirts for man T-Shirt
aliexpress.com